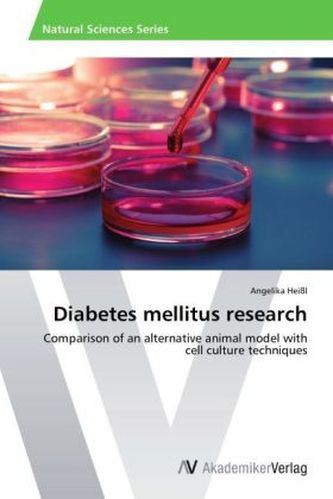

Diabetes mellitus research
21
%
809 Kč 1 018 Kč
Sleva až 70% u třetiny knih
| Autor: | |
| Nakladatel: | AV Akademikerverlag |
| Rok vydání: | 2014 |
| Jazyk : | Angličtina |
| Vazba: | Paperback / softback |
| Počet stran: | 116 |
Mohlo by se vám také líbit..